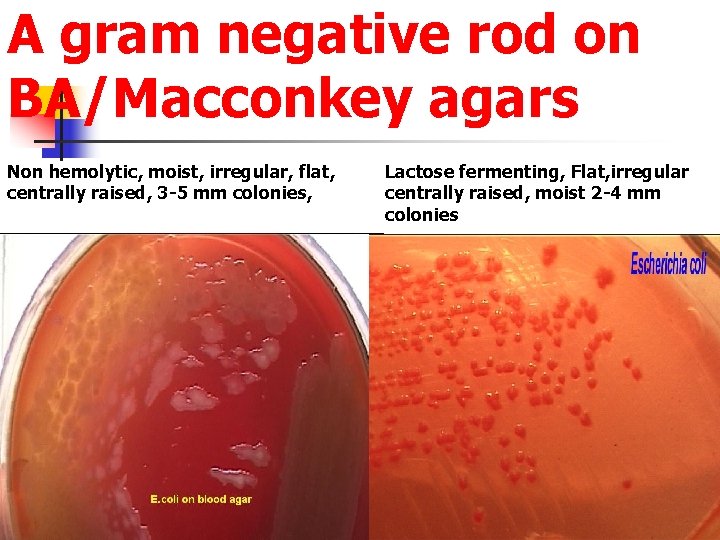
A gram negative rod on BA/Macconkey agars Non hemolytic, moist, irregular, flat, centrally raised,

PRACTICAL Identification of unknown bacterium Why species level

PRACTICAL Identification of unknown bacterium

Why species level identification required? n n n To know which species is involved in the particular condition To know the subspecies To further know the types n n Immunotypes, serotypes, chemotypes etc Epidemiological studies

Basic steps to follow Get a pure culture If pure culture is given proceed Slope is given Nutrient agar Blood agar If mixture is given Get pure culture

Pure culture follow up-Day 1 Nutrient agar slant Gram stain Growth characteristics Catalase, oxidase Purity, Pigment Motility/after 4 hours from PW/BHI If pure, S/C (1) PW (2) NA (3) BA (4) Mac

Pure culture follow up-Day 1 Blood agar slant Gram stain Growth characteristics oxidase Purity, Pigment Motility/after 4 hours from PW/BHI If pure, S/C (1) BHI (2) NA (3) BA (4) Mac

First day – preliminary findings Growth characteristics n Gram stain n Catalase n Oxidase n Motility n

Presumptive follow up Gram Negative Rods Oxidase negative Catalase positive Motile/ Nonmotile One of the members of enterobacteriaceae Oxidase Positive Catalase Positive Motile Vibrio or Pseudomonas etc

Members of enterobacteriaceae: oxidase Negative n n n n Escherichia Klebsiella Citrobacter Salmonella Shigella Proteus etc Non enterobacteriaceae Oxidase positive Vibrios Pseudomonas etc

Members of enterobacteriaceae: oxidase Negative(example) LF (ONPG) n Escherichia n Klebsiella n Citrobacter n NLF Salmonella Shigella Proteus
A gram negative rod on BA/Macconkey agars Non hemolytic, moist, irregular, flat, centrally raised, 3 -5 mm colonies, Lactose fermenting, Flat, irregular centrally raised, moist 2 -4 mm colonies

Tests to read on second day • Check whether the culture is pure • Repeat catalase, oxidase, gram and motility to confirm previous day’s findings

Biochemical tests TSI: A/A, Gas +, H 2 S Negative SIM: H 2 S, Neg, Indole: Positive. , Motile Motility; (PW) Motile It could be ESCHERICHIA, CITROBACTER, OR ENTEROBACTER Glucose : Positive (Acid and Gas) Lactose : Positive Sucrose : Negative / Positive Mannitol : Positive Macconkey: LF Indole : Positive Gram: Gram Negative rods MR : Positive LAO : +-+ VP : Positive Melonate: - Citrate : Negative Urease : Negative Catalase: Positive Oxidase ; Negative One of the members of Enterobacteriaceae KCN ; _ So it is Escherichia coli

For further details: Contact n Jasmn 98
- Slides: 13